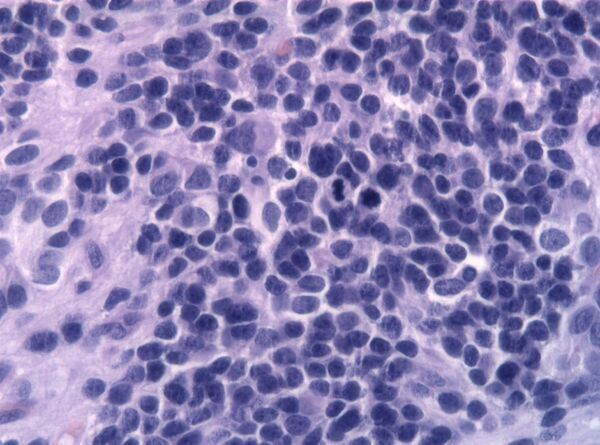

Эпендимома
Эпендимома — опухоль центральной нервной системы, которая развивается из клеток эпендимы желудочков мозга и центрального канала спинного мозга. Встречается как у детей (ежегодно выявляют 2,2 новых случая на 1 миллион населения), так и у взрослых (1,5—1,6 новых случаев)[1]. Чаще всего располагается в задней черепной ямке.
Эпендимомы — одни из немногих опухолей центральной нервной системы, которые метастазируют. Особенностью метастазирования данных новообразований является распространение опухолевых клеток по путям оттока спинномозговой жидкости[2].
Клинические проявления зависят от того, в каком отделе центральной нервной системы развивается данное новообразование. Лечение в основном комбинированное — хирургическое[3], дополняется лучевой терапией[4][5]. При тотальной резекции опухоли 5-летняя выживаемость (количество больных, которые живы через 5 лет после операции) составляет от 40[3] до 60 %[6][7]. У детей прогноз значительно хуже, чем у взрослых.
Общие сведения
Эпидемиология
Эпендимомы составляют от 5 до 14 % всех внутричерепных новообразований у детей[8][9]. В США ежегодно на 1 миллион лиц младше 16 лет выявляют 2,2 новых случая заболевания, в то время как у лиц старшего возраста — 1,5—1,6 случая[1]. Около половины общего числа эпендимом среди детей встречаются в первые 30 месяцев жизни[10]. Особых различий в заболеваемости среди мужчин и женщин нет[11][12]. Внутричерепные эпендимомы чаще всего возникают в задней черепной ямке[13][14]. Эпендимомы в области спинного мозга встречаются значительно реже внутричерепных[15][16].
Патологическая анатомия
Эпендимомы головного мозга чаще располагаются внутри желудочковой системы, реже отмечается паравентрикулярная локализация этих опухолей. Эпендимомы спинного мозга растут интрамедуллярно (внутри спинного мозга), а развивающиеся из эпендимы терминального желудочка или терминальной нити — экстрамедуллярно (вне спинного мозга). Макроскопически опухоль имеет вид чётко отграниченного узла, в котором на разрезе могут определяться крупные гладкостенные кисты. В зоне исходного роста, как правило, отсутствуют чёткие границы с тканью мозга[2].
Согласно Международной гистологической классификации 1979 года выделяют четыре типа данных новообразований[2]:
- Основным гистологическим типом является истинная эпендимома , для которой типично наличие периваскулярных и истинных «розеток». Периваскулярные «розетки» («псевдорозетки», «лучистая корона») состоят из клеток новообразования, которые располагаются вокруг кровеносных сосудов. В истинных «розетках» опухолевые клетки находятся вокруг каналов, которые выстланы эпендимарными клетками.
- Папиллярная эпендимома встречается значительно реже. Она состоит из ворсин и трабекул, которые покрыты эпендимарным эпителием. Этот тип опухоли чаще располагается экстрамедуллярно в области конского хвоста. Дифференциальную диагностику папиллярной эпендимомы необходимо проводить с хориоидпапилломой.
- Миксопапиллярная эпендимома располагается экстрамедуллярно, чаще в области конского хвоста. Для ткани данного типа опухоли характерны слизистая дистрофия, расплавление ткани и образование слизистых кист.
- Субэпендимома (синонимы: субэпендимарная узловая астроцитома, эпендимоастроцитома, эпендимоглиома) развивается из субэпендимарной глии и состоит из островков мономорфных эпендимарных клеток, которые располагаются в густом окружении глиальных бесклеточных волокон. Субэпендимома имеет форму узла и располагается внутри желудочковой системы головного мозга.
Кроме данных гистологических типов также выделяют злокачественный вариант эпендимомы — анапластическую эпендимому или эпендимобластому. Для данного типа характерны гистологические признаки анаплазии. При этой форме отмечается метастазирование опухолевых клеток по ликворным путям[2].
Более современная классификация опухолей эпендимы Всемирной организации здравоохранения 1993 года также делит данные новообразования на 4 типа[7][17]. Степень злокачественности зависит от типа эпендимомы[18][19]:
- Эпендимома (варианты: клеточная, папиллярная, эпителиальная, истинно клеточная, смешанная) — 2-я степень злокачественности
- Анапластическая эпендимома — 3-я степень злокачественности
- Миксопапиллярная эпендимома — 1-я степень злокачественности
- Субэпендимома — 1-я степень злокачественности
Клиническая картина
Опухоли боковых желудочков обычно не вызывают определённых очаговых симптомов. До повышения внутричерепного давления они ничем себя не проявляют. Первые симптомы опухолей боковых желудочков связаны с повышением внутричерепного давления: прогрессивно нарастающая головная боль, рвота, в далеко зашедших случаях — состояние оглушения, вялость, апатия, дезориентированность, грубые нарушения памяти, психические расстройства, галлюцинации. Иногда наблюдаются судорожные приступы[20].
Наиболее характерной особенностью опухолей боковых желудочков является интермиттирующее течение заболевания, и в первую очередь изменчивость интенсивности головных болей. Располагаясь в полости боковых желудочков, особенно вблизи отверстия Монро, через которое ликвор оттекает из боковых в III желудочек, опухоль в зависимости от положения головы действует как клапан. При закупорке отверстия Монро боковой желудочек выключается из общей системы ликворотока. Вследствие этого развивается односторонняя гидроцефалия, которая нередко приводит к возникновению острого гипертензионного криза. Он проявляется резкой, распирающей головной болью, рвотой, затемнением или утратой сознания. Временной закупоркой желудочка объясняют приступообразный характер головной боли, которая возникает на начальных этапах заболевания, длительные светлые промежутки. С клапанообразным механизмом закрытия отверстия Монро связывают вынужденное положение головы. Больной рефлекторно держит голову таким образом, чтобы головные боли были минимальными[20].
Наиболее частым местом расположения эпендимом является IV желудочек головного мозга. Клиническая картина опухолей IV желудочка складывается из явлений внутричерепной гипертензии, которая возникает вследствие нарушения оттока ликвора, а также очаговых симптомов. Последние возникают вследствие давления новообразования на расположенные в стенках IV желудочка структуры, то есть на ядра черепных нервов, на задний продольный пучок и на проводящие пути мозжечка[21].
В клинической картине эпендимом IV желудочка доминируют как общемозговые, так и мозжечковые симптомы, а также возникают нарушения функции черепных нервов — с V по XII включительно. Двигательные и чувствительные расстройства в большинстве случаев выражены слабо[21].
Характерным симптомом является вынужденное положение головы. У одних оно является следствием рефлекторного напряжения мышц шеи, у других — сознательного придания голове положения, при котором улучшается отток ликвора и соответственно уменьшаются головные боли[21].
Головная боль является наиболее частым симптомом эпендимом IV желудочка. Возникает она вследствие повышения внутричерепного давления — внутричерепной гипертензии. В начальных стадиях боли носят пароксизмальный характер с более или менее длительными светлыми промежутками. Приступ головной боли может возникать без всяких видимых причин, но чаще наступает после физических нагрузок, кашля, дефекации, быстрой перемены положения тела в пространстве, а также при некоторых положениях головы (чаще при запрокидывании её назад)[21].
Рвота является весьма частым симптомом заболевания. Обычно она возникает на фоне приступа головной боли, вызванной повышением внутричерепного давления. Также может наблюдаться рвота в качестве изолированного симптома, который не зависит от головной боли. В таких случаях она представляет собой очаговый симптом, так как является следствием прямого раздражения рвотного центра. Приступ может возникать при резком повороте головы. Сочетание рвоты и систематического головокружения свидетельствует о поражении вестибулярных ядер дна IV желудочка[21].
Относительно реже наблюдается систематическое головокружение. Характерно возникновение головокружения и рвоты при резком повороте головы или быстром изменении положения туловища — синдром Брунса. У ряда больных головокружение является первым симптомом заболевания[21].
Важным, хотя и неспецифическим симптомом опухолей IV желудочка являются приступы тонических судорог, или децеребрационной ригидности. Внезапно, иногда сопровождаясь криком, возникает тоническое напряжение мускулатуры конечностей, туловища и шеи. Кисть сжата в кулак, предплечья слегка согнуты, голова запрокинута назад, спина вогнута. Судороги не переходят в клонические. Приступ длится 2—3 минуты. Непроизвольного мочеиспускания и прикусов языка обычно не наблюдается[21].
Психические расстройства (вялость, раздражительность, оглушённость и т. п.) возникают в далеко зашедших стадиях заболевания. Опухоль не поражает центры, которые ответственны за психику. Однако длительное существование внутричерепной гипертензии может приводить к появлению вышеуказанных симптомов[21].
Клиническая картина заболевания, характер и длительность течения в основном определяются тем, в каком отделе IV желудочка она располагается и куда направлен её рост. Смерть обычно наступает либо из-за паралича дыхательного центра, вследствие его сдавления, либо из-за развития дислокации мозга — смещения миндалин мозжечка в затылочное отверстие[21].
Клиническая картина эпендимом спинного мозга идентична проявлениям интрамедуллярных опухолей. Она характеризуется отсутствием стадии корешковых болей. Ранним признаком являются сегментарные расстройства чувствительности. По мере роста новообразования и сдавления боковых канатиков присоединяются проводниковые двусторонние двигательные и чувствительные расстройства. Для проводниковой гипестезии при интрамедуллярной опухоли характерно распространение нарушений чувствительности сверху вниз. При поражении передних и боковых рогов спинного мозга возникают двусторонние периферические парезы, выраженные вегетативно-трофические расстройства. Признаки блокады субарахноидального пространства присоединяются относительно поздно. Течение интрамедуллярных опухолей по сравнению с экстрамедуллярными более быстрое[22].
Опухоли конского хвоста проявляются интенсивными корешковыми болями с иррадиацией в ягодицу и ногу. Усиливаются в положении лёжа. Сначала появляются односторонние, а затем и двусторонние боли. Расстройства чувствительности асимметричны. Двигательные нарушения возникают в виде периферических парезов и параличей в дистальных отделах нижних конечностей. Тазовые нарушения проявляются в виде задержки мочи[22].
Диагностика
Компьютерно-томографическая картина эпендимом включает очаг (как небольших, так и значительных размеров) умеренного повышения плотности. Очаг имеет округлую форму с относительно ровными контурами и зонами понижения плотности внутри, за счёт формирования кист. Введение контрастных веществ в большинстве случаев вызывает повышение сигнала на компьютерных томограммах. Отёк вокруг новообразования небольшой или отсутствует. В половине случаев в зоне опухоли определяют петрифицированные участки различных размеров[23].
Так как эпендимомы, как правило, связаны со стенкой желудочка, их рост вызывает деформацию или окклюзию желудочковой системы и сопутствующую гидроцефалию. Перивентрикулярный отёк наблюдается крайне редко, только в случаях запущенной гидроцефалии. В тех случаях, когда эпендимома имеет равномерную плотность, её трудно отличить от внутрижелудочковой менингиомы. При дифференциальной диагностике необходимо учитывать, что эпендимомы имеют бугристую поверхность, в то время как менингиомы чаще являются новообразованиями правильной округлой формы[23].
В типичных случаях на МРТ эпендимомы видны в виде объёмных образований, которые заполняют, а иногда и полностью тампонируют полость IV желудочка и распространяются в большую затылочную цистерну или боковую цистерну моста. Солидная часть новообразования на Т1-взвешенных томограммах выглядит изо- или даже гипоинтенсивной и гиперинтенсивной на Т2-взвешенных томограммах[24].
Дифференциальная диагностика эпендимом с другими глиомами основывается в основном на их локализации и топографии, а не на различиях интенсивности сигнала или степени контрастного усиления[25]. Кистозный компонент имеет гипоинтенсивный сигнал на Т1-взвешенных МРТ и гиперинтенсивный по отношению к мозгу на изображениях, взвешенных по Т2. Гетерогенность структуры опухоли обусловлена наличием кист, петрификатов, опухолевой сосудистой сети. После введения контраста отмечается негомогенное усиление средней интенсивности[26]. Дифференциальную диагностику эпендимом боковых желудочков необходимо проводить с медуллобластомами и астроцитомами[23].
Анапластические эпендимомы отличаются более выраженной гетерогенностью сигнала, нечёткостью границ, большим распространением, интенсивным накоплением контраста и наличием зон некроза[24].
| Медуллобластома | Эпендимома | Астроцитома задней черепной ямки | |
|---|---|---|---|
| Расположение | По средней линии | По средней линии | Эксцентрично |
| Место исходного роста | Верхний мозжечковый парус | Эпендима IV желудочка | Полушария мозжечка |
| Возраст | 3—15 | 2—10 | 10—20 |
| Образование кист | Редко | Часто | Отсутствует |
| Субарахноидальное метастазирование | 25—30 % | Редко | Редко |
| КТ без контраста | Гиперденсность | Изоденсность | Гиподенсность |
| Кальцификация | Нечасто (10—15 %) | Часто (40—50 %) | Нечасто (<10 %) |
| МРТ (режим Т2) | Средняя интенсивность | Средняя интенсивность | Гиперинтенсивность |
| Накопление контраста | Умеренное | Умеренное | Интенсивное |
Медленный рост эпендимом, особенно на уровне конского хвоста, может приводить к появлению рентгенологически видимых костных изменений — симптома Эльсберга-Дайка, деформации задней поверхности позвонков. При миелографии с водорастворимыми контрастными веществами выявляется утолщение спинного мозга в области опухоли с различной степенью выраженности сдавления субарахноидального пространства[27].
Компьютерная томография без контрастирования в диагностике эпендимом спинного мозга малоинформативна, так как изоденсную ткань опухоли сложно дифференцировать от нормальной ткани мозга. При внутривенном введении контрастных веществ идентификация ткани опухоли улучшается[27].
С помощью магнитно-резонансной томографии возможно чётко выявить увеличение в размерах спинного мозга с разграничением солидного узла и кистозной части[28][29][30].
На Т1-взвешенных томограммах при расположении опухоли на шейном и грудном уровнях определяется фузиформное утолщение спинного мозга с зоной гетерогенного изменения сигнала от ткани новообразования и сопутствующих кист. Эпендимома имеет, как правило, изо- или гипоинтенсивный сигнал по отношению к веществу спинного мозга. Для эпендимом корешков конского хвоста типично солидное строение. На МРТ хорошо определяется опухоль, которая заполняет просвет позвоночного канала, конус спинного мозга обычно смещён. Небольшие солидные эпендимомы на этом уровне сложно дифференцировать с невриномами корешков конского хвоста[27].
На Т2-взвешенных томограммах проявления эпендимом не являются специфичными. Солидная часть в большинстве случаев имеет гиперинтенсивный сигнал, однако её яркость меньшая по сравнению с кистозными компонентами. Перитуморальный (околоопухолевый) отёк определяется как зона повышения сигнала, имеет форму конуса, который основанием направлен в сторону новообразования[27].
При остром и подостром кровоизлиянии в строму эпендимомы определяются очаги повышения сигнала на Т1-взвешенных изображениях. Типичным МР проявлением перенесённого ранее кровоизлияния является ободок снижения сигнала, который лучше выявляется в режиме Т2 по периферии опухоли. Его появление обусловлено отложением гемосидерина[27].
При внутривенном усилении с помощью контрастных веществ отмечается быстрое и достаточно гомогенное повышение интенсивности сигнала от опухолевой ткани. Значительно улучшаются дифференцировка компонентов эпендимомы и её отграничение от перитуморального отёка[31][32][33].
В редких случаях эпендимомы вырастают до гигантских размеров с выраженным экстрамедуллярным компонентом[27]. Также возможно метастазирование опухолевых клеток эпендимомы по субарахноидальному пространству спинного мозга в виде множественных экстрамедуллярных узлов различного размера, что является характерным для анапластической формы новообразования[34].
Лечение
Целью операции является максимальное удаление внутричерепной части опухоли с тем, чтобы у больного не возник неврологический дефицит. Если эпендимома прорастает в дно IV желудочка, что отмечается в 50 % случаев[35], её тотальное удаление становится невозможным. После операции ликвор отправляют на цитологическое исследование с целью определить наличие и количество в нём опухолевых клеток. Доступ к образованиям IV желудочка осуществляется путём срединного субокципитального доступа[3].
Предоперационная подготовка включает установку вентрикулоперитонеального шунта[36]. При обструкции опухолью ликворопроводящих путей операция по установке шунта позволяет вывести избыточный ликвор[7].
Послеоперационные осложнения включают повреждение черепных нервов, усиление выраженности атаксии, мутизм[26][35][37][38][39]. Мутизм представляет собой состояние, при котором находящийся в ясном сознании человек не может говорить. Может возникать при поражении червя мозжечка. В большинстве случаев данное состояние регрессирует в течение нескольких месяцев.
Удаление эпендимом спинного мозга производится с применением заднего доступа. После ламинэктомии (удаления задних отделов позвоночника) вскрывается твёрдая мозговая оболочка. Срединный разрез спинного мозга над тканью эпендимомы позволяет её визуализировать. После этого производится по возможности тотальное удаление новообразования[40].
Эпендимомы являются вторыми по радиочувствительности опухолями мозга после медуллобластом[3]. Лучевая терапия назначается после хирургического удаления основного очага новообразования. Отмечено, что проведение лучевой терапии в послеоперационном периоде увеличивает среднюю выживаемость на 2 года[41]. Рекомендуемая доза радиации на ложе опухоли составляет в среднем 48 Гр[4].
В случаях обнаружения клеток эпендимомы в ликворе и/или наличия метастазов в спинном мозге проводится его дополнительное облучение[3]. Средняя доза составляет около 30 Гр[3][4]. Облучение спинного мозга с профилактической целью не показано[4][5].
В литературе также имеются данные об использовании радиохирургии в послеоперационном облучении неудалённых остатков опухоли[7]. Преимуществом радиохирургии по сравнению с лучевой терапией является прицельность её воздействия. С помощью лучевой терапии возможно облучать большие объёмы ткани, что особенно актуально при эпендимомах вследствие их возможного метастазирования.
При впервые диагностированных эпендимомах практически не применяется. В случае рецидива химиотерапия может задержать развитие опухоли на короткое время[3].
Прогноз
Послеоперационная летальность составляет 5—8 %[3]. При тотальной резекции опухоли 5-летняя выживаемость составляет от 40 до 60 %[3][6][7].
Негативными прогностическими факторами являются[7]:
- Возраст менее 5 лет. У детей 5-летняя выживаемость составляет 20—30 %[42];
- Расположение опухоли в области задней черепной ямки;
- Анапластический тип опухоли;
- Субтотальное удаление во время операции.
К положительным прогностическим факторам соответственно относят[7]:
- Возникновение опухоли у взрослого человека. 5-летняя выживаемость в данной группе достигает 80 %[3];
- Расположение новообразования над намётом мозжечка (супратенториально);
- Отсутствие признаков анаплазии согласно гистологическому исследованию;
- Тотальное удаление во время операции.
См. также
Примечания
- ↑ 1 2 Davis FG, Malinski N, Haenszel W, Chang J, Flannery J, Gershman S, Dibble R, Bigner DD. Primary brain tumor incidence rates in four United States regions, 1985-1989: a pilot study // Neuroepidemiology. — 1996. — Т. 15. — С. 103—112. — PMID 8684582.
- ↑ 1 2 3 4 Вихерт Т. М., Кадашев Б. А. Эпендимома // Большая медицинская энциклопедия / под общей редакцией Б. В. Петровского. — 3-е издание. — М.: «Советская энциклопедия», 1986. — Т. 28. — С. 271—272. — 544 с. — 150 000 экз.
- ↑ 1 2 3 4 5 6 7 8 9 10 Гринберг Марк С. Глава 14. Первичные опухоли мозга. 14. 2. 15. Эпендимома // Нейрохирургия. — М.: МЕДпресс-информ, 2010. — С. 488—490. — 1008 с. — 1000 экз. — ISBN 978-5-98322-550-3.
- ↑ 1 2 3 4 Shaw E. G., Evans R. G., Scheithauer B. W., Ilstrup D. M., Earle J. D. Postoperative radiotherapy of intracranial ependymoma in pediatric and adult patients // Int J Radiat Oncol Biol Phys. — 1987. — Т. 13. — С. 1457—1462. — PMID 3624024.
- ↑ 1 2 Vanuytsel L., Brada M. The role of prophylactic spinal irradiation in localized intracranial ependymoma // Int J Radiat Oncol Biol Phys. — 1991. — Т. 21. — С. 825—830. — PMID 1831193.
- ↑ 1 2 Sanford R. A., Gajjar A. Ependymomas // Clin Neurosurg. — 1997. — С. 559—570. — PMID 10080027.
- ↑ 1 2 3 4 5 6 7 Maksoud Y. A., Hahn Y. S., Engelhard H. H. Intracranial ependymoma // Neurosurg Focus. — 2002. — Т. 13 (3), № e4. — PMID 15844876.
- ↑ Gjerris F, Agerlin N, Børgesen SE, Buhl L, Haase J, Klinken L, Mortensen AC, Olsen JH, Ovesen N, Reske-Nielsen E, Schmidt K. Epidemiology and prognosis in children treated for intracranial tumours in Denmark 1960-1984 // Childs Nerv Syst. — 1998. — Т. 14. — С. 302—311. — PMID 9726580.
- ↑ Tomita T. Neurosurgical perspectives in pediatric neurooncology // Childs Nerv Syst. — 1998. — Т. 14. — С. 94—96. — PMID 9579861.
- ↑ Healey EA, Barnes PD, Kupsky WJ, Scott RM, Sallan SE, Black PM, Tarbell NJ. The prognostic significance of postoperative residual tumor in ependymoma // Neurosurgery. — 1991. — Т. 28. — С. 666—671. — PMID 1876244.
- ↑ Kovalic JJ, Flaris N, Grigsby PW, Pirkowski M, Simpson JR, Roth KA. Intracranial ependymoma long term outcome, patterns of failure // J Neurooncol. — 1993. — Т. 15. — С. 125—131. — PMID 8509817.
- ↑ Jayawickreme DP, Hayward RD, Harkness WF. Intracranial ependymomas in childhood: a report of 24 cases followed for 5 years // Childs Nerv Syst. — 1995. — Т. 11. — С. 409—413. — PMID 7585670.
- ↑ Schiffer D, Chiò A, Cravioto H, Giordana MT, Migheli A, Soffietti R, Vigliani MC. Ependymoma: internal correlations among pathological signs: the anaplastic variant // Neurosurgery. — 1991. — Т. 29. — С. 206—210. — PMID 1886658.
- ↑ Foreman NK, Love S, Thorne R. Intracranial ependymomas: analysis of prognostic factors in a population-based series // Pediatr Neurosurg. — 1996. — Т. 24. — С. 119—125. — PMID 8870014.
- ↑ Rezai AR, Woo HH, Lee M, Cohen H, Zagzag D, Epstein FJ. Disseminated ependymomas of the central nervous system // J Neurosurg. — 1996. — Т. 85. — С. 618—624. — PMID 8814165.
- ↑ Sgouros S, Malluci CL, Jackowski A. Spinal ependymomas — the value of postoperative radiotherapy for residual disease control // Br J Neurosurg. — 1996. — Т. 10. — С. 559—566. — PMID 9115651.
- ↑ Rosenblum MK. Ependymal tumors: A review of their diagnostic surgical pathology // Pediatr Neurosurg. — 1998. — С. 160—165. — PMID 9705595.
- ↑ Stephen B. Tatter. The new WHO Classification of Tumors affecting the Central Nervous System (англ.). сайт Массачусетского госпиталя Гарвардского университета. Дата обращения: 30 января 2012. Архивировано из оригинала 30 января 2012 года.
- ↑ Carson B. S., Guarnieri M. Chapter 58. Ependymoma // Youmans Neurological Surgery / edited by H. R. Winn. — 5th ed.. — Philadelphia: Elsevier Inc., 2004. — Т. 1. — С. 1043—1051. — ISBN 0-7216-8291-x.
- ↑ 1 2 Раздольский И. Я. Опухоли боковых желудочков // Клиника опухолей головного мозга. — Ленинград: Медгиз, 1957. — С. 87—90. — 224 с. — 10 000 экз.
- ↑ 1 2 3 4 5 6 7 8 9 Раздольский И. Я. Опухоли IV желудочка // Клиника опухолей головного мозга. — Ленинград: Медгиз, 1957. — С. 147—155. — 224 с. — 10 000 экз.
- ↑ 1 2 Гусев Е. И., Коновалов А. Н., Бурд Г. С. Опухоли спинного мозга // Неврология и нейрохирургия. — М.: Медицина, 2000. — С. 431—432. — 656 с. — 20 000 экз. — ISBN 5-225-00969-7.
- ↑ 1 2 3 Коновалов А. Н., Корниенко В. Н., Пронин И. Н. Внутримозговые опухоли. Эпендимома // Магнитно-резонансная томография в нейрохирургии. — М.: Видар, 1997. — С. 116—119. — 472 с. — 1500 экз. — ISBN 5-88429-022-5.
- ↑ 1 2 3 Коновалов А. Н., Корниенко В. Н., Пронин И. Н. Опухоли задней черепной ямки. Эпендимомы // Магнитно-резонансная томография в нейрохирургии. — М.: Видар, 1997. — С. 264—267. — 472 с. — 1500 экз. — ISBN 5-88429-022-5.
- ↑ Spoto GP, Press GA, Hesselink JR, Solomon M. Intracranial ependymoma and subependymoma: MR manifestations // AJR Am J Roentgenol.. — 1990. — Т. 154. — С. 837—845. — PMID 2107685.
- ↑ 1 2 Lyons MK, Kelly PJ. Posterior fossa ependymomas: report of 30 cases and review of the literature // Neurosurgery. — 1991. — Т. 28. — С. 659—664. — PMID 1876243.
- ↑ 1 2 3 4 5 6 Коновалов А. Н., Корниенко В. Н., Пронин И. Н. Заболевания и повреждения спинного мозга и позвоночника. Эпендимомы // Магнитно-резонансная томография в нейрохирургии. — М.: Видар, 1997. — С. 405—409. — 472 с. — 1500 экз. — ISBN 5-88429-022-5.
- ↑ Carsin M., Gandon Y., Rolland Y., Simon J. MRI of the spinal cord: intramedullary tumours // J Neuroradiol. — 1987. — Т. 14. — С. 337—349. — PMID 3450798.
- ↑ Miyasaka K., Akino M., Abe S., Isu T., Iwasaki Y., Abe H. Computed tomography and magnetic resonance imaging of intramedullary spinal cord tumors // Acta Radiol (Suppl.). — 1986. — Т. 369. — С. 738—740. — PMID 2980612.
- ↑ Goy A. M., Pinto R. S., Raghavendra B. N., Epstein F. J., Kricheff I. I. Intramedullary spinal cord tumors: MRI with emphasis on associated cysts // Radiology. — 1986. — Т. 161. — С. 381—386. — PMID 3763905.
- ↑ Bydder G. M., Brown J., Niendorf H. P., Young I. R. Enhancement of cervical intraspinal tumors in MR imaging with intravenous gadolinium-DTPA // J Comput Assist Tomogr. — 1985. — Т. 9. — С. 847—851. — PMID 2993381.
- ↑ Parizel P. M., Balériaux D., Rodesch G., Segebarth C., Lalmand B., Christophe C., Lemort M., Haesendonck P., Niendorf H. P., Flament-Durand J., et al. Gd-DTPA-enhanced MR imaging of spinal tumors // AJR Am J Roentgenol.. — 1989. — Т. 152. — С. 1087—1096. — PMID 2705343.
- ↑ Slasky B. S., Bydder G. M., Niendorf H. P., Young I. R. MR imaging with gadolinium-DTPA in the differentiation of tumor, syrinx, and cyst of the spinal cord // J Comput Assist Tomogr.. — 1987. — Т. 11. — С. 845—850. — PMID 3655047.
- ↑ Sze G., Abramson A., Krol G., Liu D., Amster J., Zimmerman R. D., Deck M. D. Gadolinium-DTPA in the evaluation of intradural extramedullary spinal disease // AJR Am J Roentgenol. — 1988. — Т. 150. — С. 911—921. — PMID 3258107.
- ↑ 1 2 Hahn Y. S., Ciro E. Family and the child with a posterior fossa tumor // Posterior Fossa Tumors / Raimondi A. J., DiRocco C. (eds). — New York, 1993. — P. 201—210.
- ↑ Hoffman H. J. Tumors of the fourth ventricle: technical considerations in tumor surgery // Clin Neurosurg. — 1988. — Т. 34. — С. 523—545. — PMID 3288411.
- ↑ Pollack I. F., Polinko P., Albright A. L., Towbin R., Fitz C. Mutism and pseudobulbar symptoms after resection of posterior fossa tumors in children: incidence and pathophysiology // Neurosurgery. — 1995. — Т. 37. — С. 885—893. — PMID 8559336.
- ↑ Sanford R. A., Kun L. E., Heideman R. L., Gajjar A. Cerebellar pontine angle ependymoma in infants // Pediatr Neurosurg. — 1997. — Т. 27. — С. 84—91. — PMID 9520080.
- ↑ Tomita T., McLone D. G., Das L., Brand W. N. Benign ependymomas of the posterior fossa in childhood // Pediatr Neurosurg. — 1988. — Т. 14. — С. 277—285. — PMID 3270047.
- ↑ Brotchi J., Fischer G. Spinal cord ependymomas // Neurosurgical Focus. — 1998. — Т. 4, № 5. — С. Article 2. — PMID 17154451.
- ↑ Mork S. J, Loken A. C. Ependymoma: a follow-up study of 101 cases // Cancer. — 1977. — Т. 40. — С. 907—915. — PMID 890671.
- ↑ Sutton L. N., Goldwein J., Perilongo G., Lang B., Schut L., Rorke L., Packer R. Prognostic factors in childhood ependymomas // Pediatr Neurosurg. — 1991. — Т. 16. — С. 57—65. — PMID 2132926.